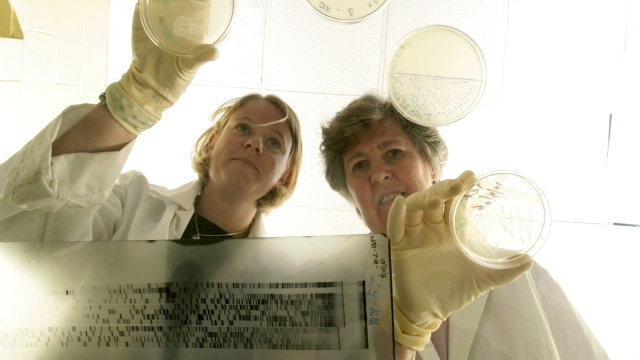

A laboratory syllabus of clinical pathology. Students are taught directly.

You may have already requested this item.

DOWNLOAD PDF A Laboratory Syllabus Of Clinical Pathology Free. Please select ok if you would like to proceed with this request anyway. Diploma in clinical pathology eligibility top colleges syllabus duration salary diploma in clinical pathology is a 2 year diploma program the minimum eligibility for which is bachelor degree from recognized institutes and colleges or its equivalent exam. The texas am institute for preclinical studies clinical pathology laboratory provides clinical pathology and diagnostic data to support preclinical research utilizing a variety of animal species.
The clinical pathology service provides first hand experience of diagnostic evaluation of clinical pathology data for common and complex diseases of small large and exotic animals. Serum biochemistry urinalysis coagulation times and cytology alongside the clinical pathologist and resident on clinical duty. The clinical pathology laboratory is in the department of population medicine and diagnostic sciences and is also a unit of the animal health diagnostic center at cornell university.
Students will be able to research develop and present a laboratory medicine case study with relevant clinicopathologic correlation at clinical pathology case conference. Add tags for a laboratory syllabus of clinical pathology. 2 pathology laboratory manuals.
The laboratory is staffed by four clinical pathologists all of whom are board certified by the american college of veterinary pathologists a laboratory manager multiple medical technologists and veterinary technicians and three administrative assistants. The student will describe and demonstrate proper handling techniques for hematology coagulation clinical chemistry and urine samples demonstrate the proper procedures for shipping medical specimens to a diagnostic laboratory and discuss the significance and implementation of quality control measures in a laboratory. The laboratory operates according to fda good laboratory practices glp for nonclinical laboratory studies and is staffed with board certified.
Students will be able to provide basic interpretation of laboratory test results for tests they were exposed to while on the clinical pathology service. Author affiliations by charles e. Simon ba md professor of clinical pathology in the school of medicine and the college of physicians and surgeons of the university of maryland baltimore.
Anatomic pathology and clinical pathology rotations are integrated throughout the four year curriculum to allow continuous exposure to both anatomic pathology and laboratory medicine facilitating subspecialty decisions and allowing residents to make and maintain relationships with mentors in the department.
 Clinical Pathology Wikipedia
Clinical Pathology Wikipedia
 Pdf Introduction To Clinical Pathology A Brief Course Of
Pdf Introduction To Clinical Pathology A Brief Course Of
 Residency In Clinical Pathology Cornell University College
Residency In Clinical Pathology Cornell University College
 Clinical And Laboratory Update In Thrombosis And
Clinical And Laboratory Update In Thrombosis And
 Department Of Pharmacy Syllabus
Department Of Pharmacy Syllabus

 Clinical Pathology Texas Am Veterinary Medical Teaching
Clinical Pathology Texas Am Veterinary Medical Teaching
 Certificate Programs
Certificate Programs
 Residency In Clinical Pathology Cornell University College
Residency In Clinical Pathology Cornell University College
 Buy A Laboratory Syllabus Of Clinical Pathology Book Online
Buy A Laboratory Syllabus Of Clinical Pathology Book Online
 A Laboratory Syllabus Of Clinical Pathology Springer
A Laboratory Syllabus Of Clinical Pathology Springer
 Laboratory Medicine Clinical Pathology Hematology And
Laboratory Medicine Clinical Pathology Hematology And
Clinical Laboratory Sciences Bachelor Of Science St
Clinical Laboratory Sciences Bachelor Of Science St
Run I2 Test Panels Quickly Economically Without A
 Syllabus College Of Medicine Ay 2015 2016
Syllabus College Of Medicine Ay 2015 2016
![[free Download] Exploring Scrying [free Download] Exploring Scrying](https://blogger.googleusercontent.com/img/b/R29vZ2xl/AVvXsEiA3tE8ur4MrnNM5a-hfrs4UnQPF8LngNv0Y5QFIyBGq9ji1t9q04Fd6naDLl5qxlNlVAmLJ1vRJQMJ3ANl1YuHmEDsHeCZVJbvpwpG92NeXZuKs1E7QsgR1FvcSR3zLACAYSb35kTuYUUY/s72-c/Twardowski_mirror.jpg)